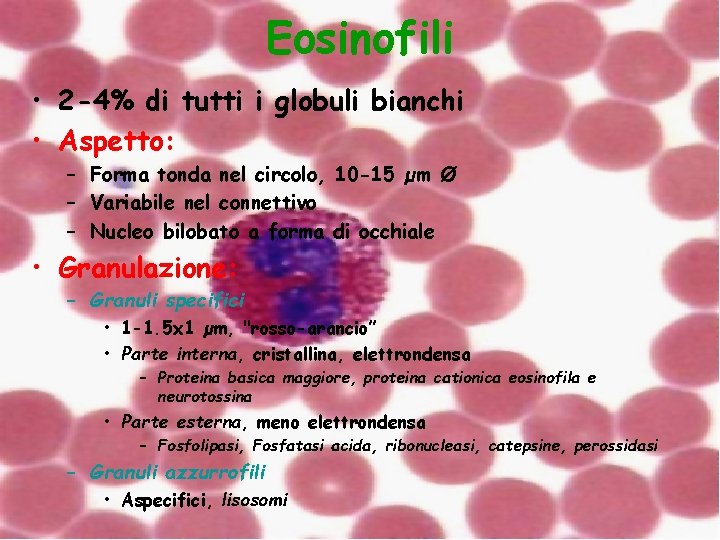
Eosinofili • 2 -4% di tutti i globuli bianchi • Aspetto: – Forma tonda

Sangue ed Ematopoiesi Le Cellule del Sangue e

- Slides: 82
Sangue ed Ematopoiesi Le Cellule del Sangue e la loro Origine
Plasma % in Peso (% in peso) % in Volume (5 litri) Altri fluidi e tessuti 92% Albumine 58% Proteine 7% Globuline 38% Acqua 91% Plasma 55% Fibrinogeno 4% Ioni Nutrienti Prodotti di Rifiuto Gas Sostanze regolatrici (ormoni) Composizione del sangue Sangue 8% Altri soluti 2% Elementi Figurati 45% (x mm 3) Piastrine 250 -400. 000 Globuli Bianchi 5 -20. 000 Neutrofili 60 -70% Linfociti 20 -25% Globuli Rossi 4, 2 -6, 2 milioni Monociti 3 -8% Eosinofili 2 -4% Basofili 0. 5 -1%
Sangue • • • Connettivo specializzato Fluido viscoso, leggermente alcalino, p. H 7. 4 Colore rosso Circola all’interno del distretto vascolare Plasma – Porzione liquida • Globuli Rossi, Globuli Bianchi e Piastrine – Porzione corpuscolata o figurata
Sangue • Plasma – 55% del volume – Acqua – Elettroliti – Proteine plasmatiche • Albumina • Globuline • Fibrinogeno –Sostanze trasportate dal sangue • Nutrienti • Prodotti di rifiuto • Gas della respirazione • Ormoni
Proteine del Plasma • Albumina – Prodotta dal Fegato, mantiene pressione osmotica e trasporta metaboliti insolubili • Globuline – e , prodotte dal Fegato, trasporto legano lipidi e vitamine liposolubili – , prodotte da plasmacellule, anticorpi • Proteine della coagulazione ioni metallici, proteine che della difesa immunitaria – Protrombina e fibrinogeno, prodotte dal Fegato • Proteine del complemento – C 1 -C 9, prodotte dal Fegato, difesa microorganismi e risposta infiammatoria • Lipoproteine plasmatiche – Chilomicromi, trigliceridi al fegato – Lipoproteine a densità molto bassa (VLDL), trigliceridi dal fegato alle cellule – Lipoproteine a bassa densità (LDL), colesterolo dal fegato alle cellule
Elementi Figurati • Eritrociti (Globuli Rossi) • 99% delle cellule • Trasportano Ossigeno • Leucociti (Globuli Bianchi) – Proteggono dalle infezioni e insorgenza tumori – Granulari • Polimorfonucleati • Neutrofili, basofili, eosinofili – Agranulari • Lnfociti e Monociti • Piastrine – Frammenti cellulari, coagulazione
Eritrociti (Globuli Rossi) • 4 -5 x 106/mm 3 • Non-nucleati, nucleo perso durante la maturazione • Forma di disco biconcavo • Dimensioni circa 8 x 2 µm • Contengono: – Emoglobina – ATP, lipidi, anidrasi carbonica • Trasporto ossigeno dai polmoni ai tessuti ed anidride carbonica dai tessuti ai polmoni
Eritrociti
Eritrociti Emoglobina • Grossa proteina tetramerica, composta da 4 catene legate covalentemente ad un gruppo Eme • Trasportatore dei gas respiratori – – Ossiemoglobina, legata all’ossigeno Carbaminoemoglobina, legata alla CO 2 – Trasporta anche ossido nitrico (NO) • 4 tipi di globine, – Feto: Hb. F, – Adulto: • Hb. A 1, 96% del totale • Hb. A 2, , 2% del totale • Hb. F, restante 2%
Eritrociti Membrana cellulare • Molto flessibile, resistente alle forze tangenziali • Proteine 50% (prevalentemente integrali) – Glicoforina A – Canali ionici, potassio calcio-dipendenti e Na+-K+ ATP – Trasportatori anioni, Banda 3 (ancoraggio anchirina) – Banda 4. 1 (ancoraggio glicoforine) • Lipidi 40% • Carboidrati 10%, superficie extracellulare, antigenici (A e B), determinano gruppo sanguigno • Rh (macacus rhesus) complesso gruppo di antigeni (C, D, E) 85% Rh+
Eritrociti
Citoscheletro • Reticolo esagonale di tetrameri di spectrina, actina, adducina, ancorato ad ankirina e banda 4. 1 • Contribuisce al mantenimento della forma e dell’inegrità strutturale e funzionale Complesso di giunzione Adducina Actina Spectrina Actina Banda 4. 1 Ankirina Banda 4. 1 Spectrina Banda 3 Tropomiosina Glicoforina
Anemia • Condizione patologica in cui la concentrazione di emoglobina e al di sotto del normale – Minor numero di Eritrociti • Anemia aplastica – Depressione del midollo osseo a causa di tumore, radiazioni o trattamento medico • Anemia Emorragica • Anemia Emolitica – Infezione Batterica
Altre anemie Associate alla dieta • Anemia perniciosa – Incapacità ad assorbire vitamina B 12 • Anemia da deficienza di ferro – Sanguinamento prolungato – Cellule pallide (ipocromiche) e piccole (microcitiche)
Eritrociti Anormali • Cambiamenti Osmotici – Difetto funzionalità renale • Difetti genetici a carico dell'emoglobina – Anemia falciforme – Talassemia • Elissocitosi e Sferocitosi – Deficienza di spettrina nella membrana cellulare
• Aumento degli eritrociti circolanti Policitemia – Aumento della viscosità del sangue che ostacola la circolazione – Policitemia secondaria • Causata dall'altitudine, bassi livelli ossigeno – Policitemia vera • Cancro al midollo provoca aumento degli eritrociti • Aumento dei reticolociti – Precursori nucleati degli eritrociti – Emorragia – Recenti ascese in alta quota
Rimozione degli Eritrociti • • Vita media = 120 giorni Intero sistema circolatorio almeno 100. 000 volte • Milza o fegato • Eritrofago – Una forma patologica di neutrofilo
Leucociti • Sono le cellule bianche del sangue • 5. 000 -20. 000/mm 3 • Non svolgono funzioni nel circolo, ma lo usano per spostarsi. A destinazione escono attraverso endotelio dei vasi e vanno nel connettivo dove funzionano • Forma tonda nei vasi, mentre varie forme nel connettivo • Funzione di difesa dell’organismo da sostanze estranee (microorganismi), rimozione cellule morte e residui cellulari
Leucociti • Si possono classificare in: – Granulociti, granuli specifici nel citoplasma • Neutrofili, piccole cellule fagocitiche • Basofili, rilascio istamina, aumento della risposta infiammatoria • Eosinofili, diminuzione della risposta infiammatoria – Agranulociti o agranulari, non presentano granuli citoplasmatici • Linfociti, immunità • Monociti, divengono Macrofagi
Neutrofili • • Sono i leucociti più comuni, 60 -70% Sono fagociti, distruggono i batteri che invadono il connettivo • Aspetto: – Nucleo Multilobato, leucociti polimorfonucleati, 35 lobi connessi da sottili tratti di cromatina, aumentano con l’età • Cromosoma X inattivo, cromatina condensata a forma di “bacchetta di tamburo” (drumstick) o corpo di Barr – Diametro 9 -12 µm – Granuli citoplasmatici
Drumstick o Corpo di Barr Nuclei Centriolo Granuli
Neutrofili • Granulazione: – Piccoli granuli specifici • 0. 1 µm Ø • Collagenasi IV, fosfolipasi A 2, lisozima, fosfatasi alcalina – Grossi granuli azzurrofili • 0. 5 µm Ø • Lisosomi contenenti idrolasi acide, mieloperossidasi, lisozima, elastasi, catepsina G e collagenasi aspecifica – Granuli terziari • Gelatinasi e catepsine, glicoproteine
• Funzione Neutrofili – Cellule molto mobili, primi ad arrivare sul luogo di un infezione – Rispondono a fattori chemiotattici • Rilasciati da tessuti danneggiati – Lasciano il circolo – Aderiscono alle selectine delle endoteliali delle venule, che vengono indotte (IL-1 e TNF) a produrre ICAM-1 a cui si legano le integrine dei neutrofili – Smettono di migrare e si preparano ad entrare nel connettivo – Producono e rilasciano leucotrieni innescando il processo infiammatorio
Fagocitosi di un batterio
• Fisiologica • • – Stress, lavoro, neonati, esercizio Infezione Infiammazione/necrosi di tessuti – Necrosi da tumore, trauma, dermatite • Droghe/sostanze chimiche – Steroidi, epinefrina, digitale, eparina • Metabolica – Acidosi daibetica, gotta, ipertiroidismo, uremia Neutrofilia
Neutropenia • • Il midollo osseo non produce le cellule Cellule non maturano (morte intramidollare) – Depressione del midollo osseo • Anemia aplastica, deficienza di vit b 12, chemioterapia, benzene, Et. OH, radiazioni – Reazione a medicinali • Cloramfenicolo, PCNS, sulfonamidi, diuretici, ipoglicemici – Trapianto di midollo – Difetto ereditario • Anemia di Fanconi, sindrome di Kostman
Ipersegmentazione • Troppe cellule mature in circolo • Focolai di infezione ed infiammazione • Ustioni • Post chemio, gravidanza
Eosinofili • 2 -4% di tutti i globuli bianchi • Aspetto: – Forma tonda nel circolo, 10 -15 µm Ø – Variabile nel connettivo – Nucleo bilobato a forma di occhiale • Granulazione: – Granuli specifici • 1 -1. 5 x 1 µm, "rosso-arancio” • Parte interna, cristallina, elettrondensa – Proteina basica maggiore, proteina cationica eosinofila e neurotossina • Parte esterna, meno elettrondensa – Fosfolipasi, Fosfatasi acida, ribonucleasi, catepsine, perossidasi – Granuli azzurrofili • Aspecifici, lisosomi
• Funzione: Eosinofili – Cellule fagocitiche con affinità per i parassiti – Contribuiscono ad eliminare i complessi antigene-anticorpo – Legame istamina, leucotrieni e fattore chemiotattico eosinofilo (dai mastociti, neutrofili e basofili) ai recettori degli eosinofili favorisce migrazione ai siti dove reazione allergica, infiammatoria e parassiti presenti – Rilascio proteina basica maggiore o cationica eosinofila, causano buchi nella parete e morte del parassita. Rilascio sostanze che inattivano iniziatori della risposta infiammatoria (istamina e lucotriene C) e fagocitano complessi antigene-anticorpo. Complessi internalizzati vengono degradati dagli endosomi
Eosinofilia • • • Neoplasia Reazioni allergiche Parassiti Eosinopenia • • • Stress acuto Infezioni Steroidi/sindrome di Cushing
Basofili – Sono i globuli leucociti meno comuni, meno dell 1% di tutti i bianchi • Aspetto: – 8 -10 µm di Ø – Nucleo ad S, spesso mascherato dalla presenza di numerosi granuli citoplasmatici • Granulazione: – Granuli specifici • Blu scuro. Si dispongono alla periferia del citoplasma dando origine al “perimetro rugoso”. • Eparina, istamina, perossidasi, fattore chemiotattico eosinofilo e neutrofilo – Granuli azzurrofili • Aspecifici • Lisosomi
Basofili • Funzione: – Reazioni di ipersensitività immediata (allergie), iniziatori della risposta infiammatoria – Recettori di membrana per le Ig. E presenti sui basofili ed i mastociti, “attivati” dal legame con Ig. E prodotte da plasmacellule. Secondo incontro con antigene induce la risposta vera e propria • Legame antigene alle Ig. E, induce rilascio dai Granuli Specifici – Fosfolipasi agisce su membrane e forma Acido Arachidonico, metabolizzato a Leucotrieni (sostanze di reazione lenta anafilattica) – Istamina provoca vasodilatazione, contrazione muscolatura liscia del respiratorio e alterata permeabilità vasi sanguigni – Leucotrieni, effetto simile ad istamina ma più lento e duraturo. Attivano leucociti e ne inducono la migrazione
Basofilia • Reazioni di ipersensibilità – Allergie, asma, eczema • Ipotiroidismo • Colite ulcerosa • Varicella Basopenia • Stress • Infezioni • Steroidi/sindrome di Cushing
Monociti – Sono le cellule più grandi del sangue. – 3 -8% di tutti i globuli bianchi. Rimangono in circolo solo pochi giorni, poi migrano nel connettivo dove differenziano in Macrofagi • Aspetto: – 10 -20 µm di Ø – Nucleo grande, eccentrico, forma a ferro di cavallo o fagiolo. Occupa circa 50% della cellula – Citoplasma grigio-azzurro con granuli azzurrofili e piccoli vacuoli
• Funzione: Monociti – Dopo aver lasciato il circolo si trasformano in Macrofagi – Sono fagociti molto efficienti, eliminano cellule morte o danneggiate (eritrociti), antigeni e batteri – Secernono citochine che attivano risposta infiammatoria, la proliferazione e la maturazione di altre cellule – Cellule che presentano l’antigene fagocitano antigeni ed espongono epitopi maggiormente antigenici alle cellule immunocompetenti – In presenza di antigeni corpuscolati molto grandi si fondono tra loro e formano le cellule giganti da corpo estraneo
Monociti • Dove funziona il sistema Monocitico. Macrofagico: – Pelle -> Cellule di Langerhan – Osso -> Osteoclasti – Fegato -> Cellule di Kuppfer – Cervello -> Microglia
Monocitosi • Infezioni – – – Tubercolosi Sifilide Salmonella Listeria Brucellosi • Tumore di Hodgkins • Disturbi Gastrointestinali – Colite ulcerosa Monocitopenia • Steroidi
Linfociti – 20 -25% di tutti i globuli bianchi • Aspetto: – Nucleo eccentrico, denso e che occupa circa il 90% della cellula – Citoplasma scarso, color blu tenue con pochi granuli azzurrofili – 8 -10 µm di Ø – Visivamente non si distinguono • Linfociti B (15%) • Linfociti T (80%) • Natural Killer (NK, 5%)
Funzione dei Linfociti – Non svolgono attività in circolo, ma nel connettivo. Acquisita la competenza migrano nei linfonodi e nella milza, dove formano cloni di cellule identiche – Dopo stimolazione mediante antigene proliferano e differenziano in due popolazioni: • Cellule con memoria, non partecipano alla risposta immunitaria, ma rimangono nel clone e sono pronte a rispondere a quell’antigene • Cellule effettrici, linfociti immunocompetenti che possono essere classificate come Linfociti B e T
• Linfociti B: – Si formano e divengono immunocompetenti nel midollo osseo – Responsabili della risposta immunitaria umorale – Possono differenziare in Plasmacellule e produrre anticorpi • Linfociti T: – Migrano dal midollo osseo al Timo dove maturano – Costituiscono il sistema immunitario, risposta cellulo -mediata • T Citotossici: contatto diretto ed uccisione cellule estranee o infette • T Helper: inizio e sviluppo della risposta immunitaria • T Suppressor: soppressione della risposta immunitaria
• Null cells: – Cellule Staminali • Circolanti ed in grado di differenziare in tutti gli elementi figurati del sangue – Natural Killer • Sono in grado di uccidere le cellule estranee o trasformate senza l’intervento dei Linfociti T
Linfocitosi • Il numero varia con gli anni • Infezione virale • Altre infezioni – – – Sifilide Toxoplasmosi Micoplasma – – – Autoimmunità Ipertiroidismo Trapianto (rigetto) • Altro Linfocitopenia • Diminuzione nella produzione – Immunodeficienza ereditaria – AIDS • Aumento dell'eliminazione – Steroidi/sindrome di Cushing – Radiazioni, chemio
Piastrine • Residui cellulari derivanti dalla rottura dei megacariociti nel midollo • 2 -4 µm di Ø, forma discoidale, regione periferica chiara detta Ialomero, regione centrale detta Granulomero • Membrana plasmatica numerosi recettori e glicocalice spesso • 250 -400. 000/mm 3 • • Presentano molti organelli ma prive di nucleo Fondamentali per la coagulazione
Anatomia di una piastrina • Sistema tubulare denso e aperto sulla superficie • Granuli – Granuli alfa • Fibrinogeno • Fattori di coagulazione – Granuli delta • Fattori aggregazione e vasocostrizione – Granuli lambda • Enzimi idrolitici, dissoluzione del coagulo Ialomero vs. Granulomero
PAUSA SIGARETTA
Coagulazione • Processo che impedisce l’emorragia in caso dei rottura dei vasi – Normalmente l’aggregazione delle piastrine impedita dalle cellule endoteliali, produzione di Prostaciclina e NO. Presenza sulla membrana di Trombomodulina e Molecole Eparino-simili – Endotelio danneggiato rilascia Fattore di Von Willebrand e Tromboplastina Tissutale e cessa produzione inibitori. Endotelina potente vasocostrittore
– Attivazione piastrinica • Piastrine aderiscono al collagene subendoteliale, rilasciano il contenuto dei granuli ed aderiscono le une alle altre • Rilascio di ADP e Trombospondina rendono le piastrine circolanti appiccicose e causano adesione a quelle già adese e la degranulazione – Acido arachidonico • Formatosi nell’attivazione, viene convertito in trombossano A 2 – Potente vasocostrittore ed attivatore delle piastrine – Piastrine aggregate funzionano da tappo ed esprimono sul plasmalemma il Fattore Piastrinico 3, superficie fosfolipidica adatta per assemblaggio fattori di coagulazione-Trombina
Attivazione dei fattori di coagulazione • Tromboplastina tessutale e piastrinica – Agisce sulla protrombina circolante e la trasformano in trombina • Trombina – Aumenta l’attivazione delle piastrine e in presenza di Ca 2+ trasforma il Fibrinogeno (solubile) in Fibrina (insolubile) • Fibrina – Monomerica si aggrega e polimerizza formando un reticolo di fibrina – Intrappola gli elementi figurati del sangue – Si forma un ammasso gelatinoso, il coagulo sanguigno (trombo) – Eritrociti facilitano l’attivazione delle piastrine, mentre neutrofili ed endoteliali la limitano, delimitando le dimensioni del trombo
• Dopo circa 1 ora, dalla formazione del coagulo, monomeri di actina e miosina formano dei filamenti sottili e spessi • Provocano la contrazione del coagulo (1/2 del volume iniziale) – Riduzione della lesione e della perdita emorragica • Una volta che il vaso è stato riparato, le endoteliali rilasciano attivatori del plasminogeno, convertono plasminogeno circolante in plasmina • Insieme ai granuli lambda (lisosomi) delle piastrine lisano il coagulo
Tessuti Ematopoietici Mieloidi • Midollo osseo: – Cavità midollare ossa lunghe e tra le trabecole delle spugnose – Consistenza gelatinosa, altamente vascolarizzato, separato dal tessuto osseo dall’endostio – 5% del peso corporeo – Dal 5° mese è responsabile della produzione di tutte le cellule del sangue Ematopoiesi – Maturazione dei linfociti B e formazione dei linfociti immaturi T – Pluripotente Cellule Staminali Ematopoietiche • Possono differenziare in tutti i tipi cellulari del sangue in seguito a stimolo appropriato
• Midollo Rosso – Nel neonato, molti eritrociti • Midollo Giallo – Nelle diafisi delle ossa lunghe dopo i 20 anni – Accumulo di grasso che sostituisce i tessuti ematopoietici • Vascolarizzazione – Arterie sfioccano in piccoli vasi che formano ampia rete di sinusoidi, confluiscono in vena longitudinale centrale e poi vasi in uscita – Tra le maglie di questo comparto vascolare si trovano isole di cellule emopoietiche, collegate tra loro a formare il comparto ematopoietico
• Sinusoidi – Tapezzati da endoteliali – Circondati da • Sottili fibre reticolari • Cellule reticolari avventiziali • Prolungamenti in direzione delle endoteliali, altri verso altre cellule reticolari in modo da formare una rete intorno alle cellule ematopoietiche. • Accumulo di grasso nel loro citoplasma le trasforma in cellule adipose, riduce volume del comparto ematopoietico e trasforma midollo da rosso a giallo • Isole ematopoietiche – Cellule ematiche a diversi stadi di maturazione – Macrofagi • Distruggono nuclei eritrociti e cellule alterate
Midollo Rosso Sinusoidi Endoteliali Codoni ematopoietici o Isole ematopoietiche Adipociti
• Prenatale Ematopoiesi – Divisa in 4 fasi – Fase mesoblastica • Mesoderma del sacco vitellino, seconda settimana vita intrauterina, le cellule mesenchimali si aggregano a formare isole sanguigne – Cellule periferiche danno origine alle pareti dei vasi, mentre le altre divengono eritroblasti e differenziano in eritrociti nucleati – Fase mesoblastica • Sesta settimana di gestazione. • Eritrociti nucleati, verso l’ottava settimana compaiono i leucociti
Ematopoiesi – Fase splenica • Secondo trimestre, prosegue fino al termine della gravidanza, insieme a quella epatica – Fase mieloide • Emopoiesi midollare • Inizia fine del secondo trimestre • Sviluppo sistema scheletrico induce midollo ad assumere ruolo predominante nella produzione delle cellule ematiche
Ematopoiesi • Postnatale – Avviene quasi esclusivamente nel midollo osseo – Produzione continua di cellule ematiche da precursori staminali • Ogni giorno più di 1011 cellule ematiche prodotte dal midollo – Cellule staminali vanno incontro a divisione e differenziamento
Ematopoiesi Cellule staminali emopoietiche pluripotenti – Circa 0, 1% delle cellule nucleate del midollo – Quiescenti, per mitosi generano • Altre cellule pluripotenti – Due tipi di staminali multipotenti, che origineranno le varie cellule progenitrici • CFU-S (Colony-Forming Unit-S) – Precursore della linea mieloide (eritrociti, granulociti, monocti e piastrine) • CFU-Ly (Colony-Forming Unit-Ly) – Precursore della linea linfoide (cellule B e T)
Ematopoiesi • Cellule progenitrici – – – Cellule unipotenti (formano una singola linea cellulare) Limitata capacità di autoriprodursi Attività mitotica e differenziamento controllati da fattori ematopoietici specifici • Cellule precursori – – – Derivano dalle progenitrici Perso la capacità autoriproduttiva Caratteristiche morfologiche permettono la loro classificazione come i primi elementi di una linea particolare – Si dividono e differenziano, originando un clone di cellule mature
Ematopoiesi • Maturazione dei precursori è caratterizzata da – Riduzione delle dimensioni – Scomparsa dei nucleoli – Addensamento della cromatina – Comparsa nel citoplasma delle caratteristiche della cellula matura (granuli)
Ematopoiesi Fattori di crescita • Regolazione dell’ematopoiesi dipende da numerosi fattori di crescita e citochine, prodotti da differenti tipi cellulari • Azione di un fattore su una particolare staminale, progenitrice o precursore ne induce proliferazione, differenziazione o ambedue
• Molti sono glicoproteine • 3 vie per raggiungere la cellula bersaglio – Tramite il circolo sanguigno • Ormoni – Secrezione da parte delle cellule stromali del midollo, in vicinanza delle cellule ematopoietiche • Ormoni paracrini – Contatto diretto cellula-cellula • Molecole segnale della superficie
• Interleuchine – Stimolano la proliferazione delle staminali pluripotenti e multipotenti, per mantenere costante il numero • IL-1, -3, -6 – Responsabili della mobilitazione e del differenziamento in progenitrici unipotenti • IL-3, -7, -8 , -11 , -12, eritropoietina, proteina inibente i macrofagi, etc
• Fattori stimolanti le colonie (CSF) – Stimolano la mitosi e la differenziazione delle cellule unipotenti della serie granulocitica e monocitica • Eritropoietina – Attiva le cellule della serie eritrocitaria • Trombopoietina – Stimola la formazione delle piastrine • Fattore delle cellule staminali – Prodotto dalle cellule stromali ed esposto sulla superficie – Agisce sulle staminali, che devono venire a contatto con le stromali – Confinamento nel midollo
Eritropoiesi • Processo tramite il quale vengono prodotti 2, 5 x 1011 eritrociti al giorno • Due tipi di progenitrici unità eritrocitarie • BFU-E (blast-forming units-erithrocyte) – Responsabili della maturazione • CFU-E (colony-forming units-erithrocyte) – Formano colonie • Abbassamento degli eritrociti circolanti, induce il rene a produrre eritropoietina
Eritropoiesi • Eritropoietina insieme a IL-3 e -9, fattore delle staminali e fattore stimolante le colonie monocitarie e granulocitarie induce differenziamento CFU-S in BFU-E • “Esplosione” mitotica BFU-E produce un elevato numero di CFU-E – Bassa concentrazione di eritropoietina per sopravvivere e generare proeritroblasto primo elemento della serie eritrocitaria
• Proeritroblasto • 14 -19 µm, nucleo rosso, cromatina sottile, mitosi, aggregati citoplasmatici grigio-blu periferici • Eritroblasto basofilo • 12 -17 µm, cromatina granulare, un po’ di emoglobina • Eritroblasto policromatofilo • 12 -15 µm, nucleo denso, cromatina molto granulare, no nucleoli, più emoglobina
• Eritroblasto ortocromatico • 8 -12 µm, nucleo piccolo tondo e denso, in fase di espulsione, molta emoglobina • Reticolocita • 7 -8 µm, nucleo assente, assomiglia alla cellula matura ma si può colorare reticolo citoplasmatico blu, ricco di emoglobina • Eritrocita • Nucleo assente, citoplasma rosa, solo emoglobina
Granulocitopoiesi • 800. 000 neutrofili, 170. 000 eosinofili e 60. 000 basofili al giorno • Unico precursore staminale unipotente origina i tre tipi di granulociti – Staminali pluripotenti CFU-Eo e CFU-Ba si dividono e originano il Mieloblasto – CFU-GM • Bipotente, origina la serie neutrofila (CFU-G) e quella Monocitaria (CFU-M) – CFU-G si divide ed origina Mieloblasto • Precursore di tutte e 3 le serie, indistinguibili tra loro • Originano i Promielociti
• Mieloblasto – 12 -14 µm, nucleo rosso-blu, cromatina sottile, mitosi. Aggregati citoplasmatici blu e processi citoplasmatici • Promielocita – 16 -24 µm, nucleo rosso-blu, cromatina granulare, mitosi. Citoplasma blu, no processi • Granuli azzurrofili
• Mielocita – 10 -12 µm, nucleo appiattito eccentrico, cromatina granulare, mitosi. Citoplasma blu pallido • Granuli specifici ed azzurrofili • Matamielocita – 10 -12 µm, nucleo forma di fagiolo, denso, cromatina granulare, no mitosi, no nucleoli. Citoplasma blu pallido • Granuli specifici ed azzurrofili
• Neutrofilo giovane – Nucleo a ferro di cavallo, cromatina molto granulare, no mitosi – Citoplasma blu pallido • Granuli specifici ed azzurrofili • Neutrofilo – Nucleo multilobato, cromatina molto granulare, no mitosi – Citoplasma rosabluastro pallido. • Granuli specifici ed azzurrofili
Monocitopoiesi • Monociti condividono con i neutrofili la stessa staminale bipotente CFU-GM • Per mitosi originano CFU-G e CFU-M (monoblasti) • Promonociti – Derivano da CFU-M – Cellule grosse (16 -18 µm), nucleo reniforme eccentrico – Citoplasma bluastro numerosi granuli azzurrofili • Si formano 1010 monociti al giorno, maggior parte entrano nel circolo • Nel giro di un paio di giorni entrano nel connettivo e differenziano in Macrofagi
Formazione delle piastrine • Progenitore unipotente CFU-Mg origina il Megacarioblasto – 25 -40 µm – Nucleo unico multilobato – Endomitosi, cellule non si dividono ma nuclei polipliodi, fino 64 N – Citoplasma bluastro con Granuli azzurrofili – Stimolato a proliferare e differenziarsi dalla trombopoietina
• Megacarioblasto differenzia in Megacariocita – 40 -100 µm – Nucleo unico plurilobato – Si dispongono vicino ai sinusoidi ed inviano al loro interno dei prolungamenti citoplasmatici – Si frammentano in seguito ad invaginazioni del plasmalemma, canali di demarcazione, e danno origine a gruppi di propiastrine – Propiastrine appena rilasciate si risolvono in singole piastrine – Rimasugli cellulari vengono fagocitati dai macrofagi
Megacariocita
Linfopoiesi • Staminali multipotenti CFU-Ly, si dividono nel midollo osseo e formano – CFU-Ly. B • Negli uccelli migrano in diverticoli intestinali (borsa di Fabrizio), e si dividono varie volte dando origine a linfociti B immunocompetenti, che esprimono marker di superfice tipici. • Nei mammiferi gli stessi eventi si verificano nel midollo osseo – CFU-Ly. T • Si dividono e danno origine a linfociti T immunocompetenti, che migrano al timo dove proliferano, maturano ed incominciano ad esprimere i marker di superficie. • Elevata selezione ad opera del timo stesso e dei macrofagi • Linfociti migrano negli organi linfoidi, milza e linfonodi, dove formano cloni di cellule immunocompetenti
Ematopoiesi Cellula Staminale Proeritroblasto Eritroblasto basofilo Mieloblasto Linfoblasto Mielocita Basofilo Eritroblasto ortocromatico Megacarioblasto Promielocita Eritroblasto policromatofilo Espulsione del nucleo Monoblasto Eosinofilo Reticolocita Megacariocita Neutrofilo Metamielocita Monocita Rottura Piastrine Eritrocita Cellule Rosse del sangue Basofilo Eosinofilo Neutrofilo Linfocita Granulociti Cellule Bianche del sangue Agranulociti